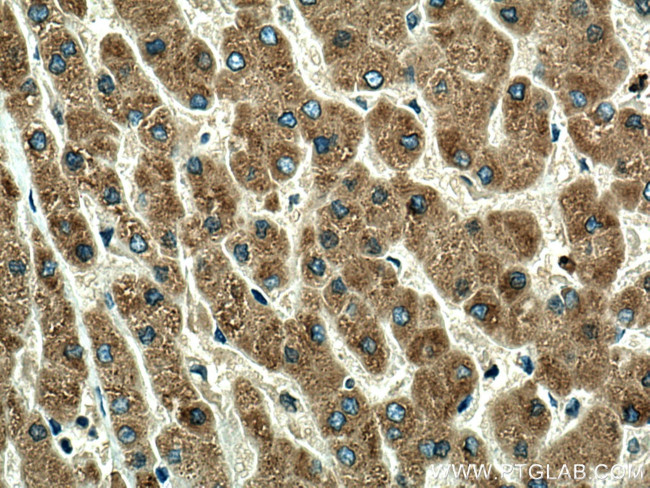
ORM1 Antibody in Immunohistochemistry (Paraffin) (IHC (P))

Search
Proteintech
ORM1 Polyclonal Antibody
{{$productOrderCtrl.translations['antibody.pdp.commerceCard.promotion.promotions']}}
{{$productOrderCtrl.translations['antibody.pdp.commerceCard.promotion.viewpromo']}}
{{$productOrderCtrl.translations['antibody.pdp.commerceCard.promotion.promocode']}}: {{promo.promoCode}} {{promo.promoTitle}} {{promo.promoDescription}}. {{$productOrderCtrl.translations['antibody.pdp.commerceCard.promotion.learnmore']}}
产品信息
16439-1-AP
种属反应
已发表种属
宿主/亚型
分类
类型
抗原
偶联物
形式
浓度
规格
纯化类型
保存液
内含物
保存条件
运输条件
产品详细信息
This antibody recognizes a band about 44 kDa in human plasma which may be due to the glycosylation of ORM1 or the dimer formation of the protein.
Immunogen sequence: NLVPVPITN ATLDRITGKW FYIASAFRNE EYNKSVQEIQ ATFFYFTPNK TEDTIFLREY QTRQDQCIYN TTYLNVQREN GTISRYVGGQ EHFAHLLILR DTKTYMLAFD VNDEKNWGLS VYADKPETTK EQLGEFYEAL DCLRIPKSDV VYTDWKKDKC EPLEKQHEKE RKQEEGES (25-201 aa encoded by BC026238 )
靶标信息
ORM1 is an acute phase plasma protein synthesized by the liver. The protein is believed to regulate the interaction between blood cells and endothelial cells, and together with haptoglobin and C reactive protein, also regulates the extravasation of the cells during infection and inflammation. ORM1 is a major acute phase reactant, both in human and in rat. In human plasma, ORM1 (44 kDa) is found at levels of 0.5-1.4 mg/mL. Its concentration in blood plasma is elevated during acute inflammation, such as trauma, malignancies, myocardial infarction, rheumatoid arthritis, bacterial infections, after major surgery, in cases of chronic pain etc, and can be used for the diagnosis of inflammatory conditions.
仅用于科研。不用于诊断过程。未经明确授权不得转售。
生物信息学
蛋白别名: AGP 1; alpha-1 acid glycoprotein precursor; Alpha-1-acid glycoprotein; Alpha-1-acid glycoprotein 1; alpha-1-acid glycoprotein-2; bM340H1.2 (orosomucoid 1); epididymis secretory sperm binding protein Li 153w; OMD; OMD 1; Orosomucoid; Orosomucoid-1; unnamed protein product
基因别名: A1AG1; AGP; Agp-1; Agp-2; AGP-A; AGP1; Agpa1; HEL-S-153w; OMD; ORM; Orm-1; ORM1
UniProt ID: (Human) P02763, (Rat) P02764, (Mouse) Q60590
Entrez Gene ID: (Human) 5004, (Rat) 24614, (Mouse) 18405